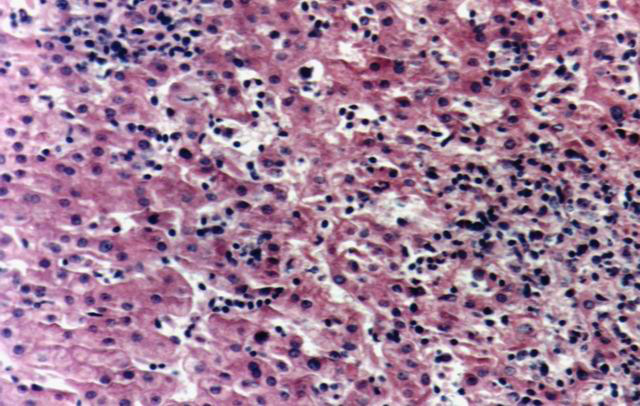

Direccion de contacto
fiogf49gjkf0d Dr. Oscar Marin.
Servicio de Anatomía Patológica, Hospital Pablo Soria de Jujuy.
Güemes 1345. S.S. de Jujuy-Argentina. 4600.
omarin100@hotmail.com
|
|
LINFOMA T HEPATOESPLENICO.
Oscar Marin*, Noriko Yamamoto**, Gabriela Lamas Hernandez***
* Hospital "Pablo Soria" de Jujuy-Argentina ARGENTINA
** The Cancer Institute, Tokyo. JAPON
*** Laboratorio de Bioquimica Caming-Jujuy ARGENTINA
|
|
|
Resumen
fiogf49gjkf0d LINFOMA T HEPATOESPLENICO.
INTRODUCCION:
Linfoma T citotóxico infrecuente que presenta características clínico patológicas distintivas, como ser pacientes adultos jóvenes, con anemia moderada, hepatoesplenomegalia y trombocitopenia. Infiltración sinusoidal por células linfomatosas en médula ósea, bajo e hígado. Presentamos un caso de este linfoma infrecuente.
METODOS:
Paciente masculino de 35 años de edad presenta fiebre, anemia moderada, trombocitopenia, neutropenia, mialgias y hepatoesplenomegalia. Sin adenopatías, lesiones cutáneas, ni masa mediastinal. Antecedente de familiar fallecido por leucemia. Se realizó la biopsia de médula ósea, esplenectomía: Bazo de 30 cm de diámetro y 3,5 kg de peso, de aspecto carnoso y, a sin delimitación de pulpa roja y blanca. Finalmente se realizó biopsia hepática. Las muestra fueron estudiadas con: Hematoxilina-Eosina, Giemsa, PAS y Gomori. Estudio inmunohistoquímico realizado sobre material esplénico: CD3, CD4, CD5, CD8, CD45RO, CD43, CD20, CD79a, cadenas livianas de inmunoglobulinas kappa, cadenas livianas de inmunoglobulinas lambda, CD56, S-100, Ki-67, p53, TIA-1, Perforina y Granzime B.
RESULTADOS:
La biopsia inicial fue en médula ósea mostrando una infiltración intersticial por linfoma de inmunofenotipo a determinar. Se realizó tratamiento de quimioterapia con Ciclofosfamida, Doxorubicina, vincristina y deltisona sin respuesta, efectuándose luego esplenectomía y segunda línea de quimioterapia con MINE (Mitoxantrona, Iofosfamida, Mesna y etopóxido). El Bazo presentó infiltración sinusoidal por células de pequeño a mediano diámetro, homogéneas, esféricas, con cromatina densa moderada índice mitótico bajo.
Inmunohistoquímica: CD3+, CD8+, CD45RO+, CD43+, CD20-, CD79a, Kappa-, Lambda-, CD56-, Ki-67-, p53-, S-100-, TIA-1+, Granzime B-, Perforina-.
Biopsia hepática: Infiltración sinusoidal y portal por elementos linfoides con similares características a la descriptas en la biopsia esplénica.
DISCUSION:
Este caso presenta los caracteres clínicos patológicos de un linfoma que Hepatoesplénico, entidad primeramente descrita como linfoma γ/δ Hepatoesplénico de cuál se ha descripto una variedad llamada linfoma α/β Hepatoesplénico. El estudio de TCR para α/β o γ/δ sólo es posible de realizar sobre materiales en fresco, no pudiendo realizarse este estudio, ya que se recibió fijado el bazo. Se diagnosticó como linfoma T Hepatoesplénico. Es el único caso de este tipo que registramos, entre 528 casos de linfomas de nuestro archivo y entre 242 casos de linfomas extraganglionares.
|
|
|
Introduccion
fiogf49gjkf0d Linfoma T citotóxico infrecuente que presenta características clínico patológicas distintivas, como ser pacientes adultos jóvenes, con anemia moderada, hepatoesplenomegalia y trombocitopenia. Infiltración sinusoidal por células linfomatosas en médula ósea, bazo e hígado.
Inicialmente referido como linfoma delta/gamma hepatoesplénico, luego comprobandose la existencia de casos con TCR de tipo alfa/beta. La denominación actual por la OMS es de linfoma T hepatoesplénico.
Linfocitos T-delta/gamma en humanos representa un sub-tipo de linfocitos T post-tímicos, con funciones citotóxicas y localización preferencial en algunos tejidos ricos en estructuras epiteliales como áreas sinsusoidales y pulpa roja esplénicas. En 1990 Gaulard y col. propsuieron el término linfoma T delta/gamma hepatoesplenico, como una entidad clinicopatológica diferente entre los linfomas T periféricos, reconocido sobre las bases de su característica presentación clínica, patente histológica resultante del trofismo de sus células hacia estructuras sinusoidales y expresión del receptor T delta/gamma por las células tumorales. Existe además una fuerte asociacón con una anomalía citogenética en el brazo corto de 7q.
A causa de la rareza de esta afección y la dificultad de comprobar la existencia del receptor delta/gamma, solo posible de realizar en fresco, no hay reportes de grandes series o estos son incompletos.
Habitualmente este linfoma es CD3+, CD5-TIA-1+, pudiendo ser CD8 positivo o negativo (mas frecuentemente) y CD56 positivo o negativo. No se reporta asociación con virus de Epstein-Barr.
Entre nuestros casos de linfomas extraganglionares encontramos solo un caso de linfoma que reune caracteres clínicos e inmunofenotípicos de linfoma T hepatoesplénico. Presentamos un caso de este linfoma infrecuente, en paciente joven de sexo masculino, presentando anemia, trombocitopenia, mialgias e infiltración linfomatosa en hígado, bazo y médula ósea, con inmunofenotipo T citotóxico.
|
|
|
Material y Métodos
fiogf49gjkf0d Paciente masculino de 35 años de edad, que presenta fiebre (38,4ºc), anemia moderada, trombocitopenia, neutropenia y hepatoesplenomegalia. Sin adenopatías, lesiones cutáneas, ni masa mediastinal. No alteraciones en fosa nasal, aparato gastrointestinal, Cavum, parótida etc. El motivo de consulta fue por Mialgias. Antecedente de familiar fallecido por leucemia. Antecedentes negativos para tuberculosis, Enfermedad de Chagas y Hepatitis.
Hematocrito de 29 %, Fórmula sanguínea eritrocitos 3.9 6, Plaquetas 22.300, leucocitos 10 %, linfocitos 86 %, monocitos 2 %. LDH 98 UI/L. Transaminasa Glutámico Pirúvica (TGP) 40 U/L, Transaminasa Glutámico Oxalacetica (TGO) 41 UI/L. Gamma G.T 125 UI/L, Fosfatasa Alcalina: 580 UI/L.
El porcentaje de linfocitos fué variable con 26 % en la primera examinación, 57 % en la segunda y ascendiendo a 57 %, 66 % y 86% en los estudios posteriores.
Se realizó biopsia de médula ósea, esplenectomía: Bazo de 30 cm de diámetro y 3,5 kg de peso, de aspecto carnoso y, sin delimitación de pulpa roja y blanca. Finalmente se realizó biopsia hepática. Las muestras fueron estudiadas con: Hematoxilina-Eosina, Giemsa, PAS y Gomori. Estudio inmunohistoquímico realizado sobre material esplénico: CD3, CD4, CD5, CD8, CD45RO, CD43, CD20, CD79a, cadenas livianas de inmunoglobulinas kappa, cadenas livianas de inmunoglobulinas lambda, CD56, S-100, Ki-67, p53, TIA-1, Perforina y Granzime B.
|
|
|
Resultados
fiogf49gjkf0d Estudio Histológico: Linfoma monomorfo de células pequeñas a medianas, infiltrando Médula Ósea, Bazo e Hígado.
Estudio Inmunohistoquímico: CD3+, CD43+, CD45RO+, CD8+, TIA-1+, CD20-, CD79a-, cadenas livianas de inmunoglobulinas kappa y lambda negativas, CD5-, S-100-, CD56-, p53-, Granzime B-, Perforina-, Ki-67-.
 fiogf49gjkf0dMédula ósea hipercelular"> fiogf49gjkf0dMédula ósea hipercelular">
Fig. 1: Biopsia medular. - fiogf49gjkf0d Médula ósea hipercelular
 fiogf49gjkf0dInfiltración medular ósea por celularidad linfoide, monótona, difusa, en sector intertrabecular."> fiogf49gjkf0dInfiltración medular ósea por celularidad linfoide, monótona, difusa, en sector intertrabecular.">
Fig. 2. Médula ósea, Hematoxilina-Eosina. - fiogf49gjkf0d Infiltración medular ósea por celularidad linfoide, monótona, difusa, en sector intertrabecular.
 fiogf49gjkf0dSe observan células monomorfas, hipercrómicas, con nucleolos insconspícuos y escaso citoplasma."> fiogf49gjkf0dSe observan células monomorfas, hipercrómicas, con nucleolos insconspícuos y escaso citoplasma.">
Fig. 3: Infiltrado linfoide medular. H-E - fiogf49gjkf0d Se observan células monomorfas, hipercrómicas, con nucleolos insconspícuos y escaso citoplasma.
 fiogf49gjkf0d"> fiogf49gjkf0d">
Fig. 4: Esplenectomía, vista a bajo aumento. - fiogf49gjkf0d
 fiogf49gjkf0dCitología monomorfa, hipercrómica, con escaso citoplasma tingible."> fiogf49gjkf0dCitología monomorfa, hipercrómica, con escaso citoplasma tingible.">
Fig. 5: Esplenectomia, vista a gran aumento. H-E - fiogf49gjkf0d Citología monomorfa, hipercrómica, con escaso citoplasma tingible.
 fiogf49gjkf0dInfiltración sinusoidal y de cordones de pulpa roja esplénico, por células CD3+."> fiogf49gjkf0dInfiltración sinusoidal y de cordones de pulpa roja esplénico, por células CD3+.">
Fig. 6: CD3. - fiogf49gjkf0d Infiltración sinusoidal y de cordones de pulpa roja esplénico, por células CD3+.
 fiogf49gjkf0dSe observan ocasionales remamentes de pulpa blanca esplénica, positivos para CD20."> fiogf49gjkf0dSe observan ocasionales remamentes de pulpa blanca esplénica, positivos para CD20.">
Fig. 7: CD20 - fiogf49gjkf0d Se observan ocasionales remamentes de pulpa blanca esplénica, positivos para CD20.
 fiogf49gjkf0dCD43 presenta inmunoreactividad en territorio similar a CD3 y CD45RO."> fiogf49gjkf0dCD43 presenta inmunoreactividad en territorio similar a CD3 y CD45RO.">
Fig. 8: CD43 - fiogf49gjkf0d CD43 presenta inmunoreactividad en territorio similar a CD3 y CD45RO.
 fiogf49gjkf0dSimilar inmunoreactividad de CD45RO, con CD3 y CD43."> fiogf49gjkf0dSimilar inmunoreactividad de CD45RO, con CD3 y CD43.">
Fig. 9: CD45RO - fiogf49gjkf0d Similar inmunoreactividad de CD45RO, con CD3 y CD43.
 fiogf49gjkf0dTejido esplénico, inmunoreactividad para CD8, en el mismo territorio que las células CD3+, pero en menor porcentaje."> fiogf49gjkf0dTejido esplénico, inmunoreactividad para CD8, en el mismo territorio que las células CD3+, pero en menor porcentaje.">
Fig. 10: CD8 - fiogf49gjkf0d Tejido esplénico, inmunoreactividad para CD8, en el mismo territorio que las células CD3+, pero en menor porcentaje.
 fiogf49gjkf0dEl estudio de proteína S-100, realizado ante la existencia de raros linfomas hepáticos S-100+, es completamente negativa."> fiogf49gjkf0dEl estudio de proteína S-100, realizado ante la existencia de raros linfomas hepáticos S-100+, es completamente negativa.">
Fig. 12: S-100 - fiogf49gjkf0d El estudio de proteína S-100, realizado ante la existencia de raros linfomas hepáticos S-100+, es completamente negativa.
fiogf49gjkf0dInfiltración de sinusoides y espacios porta por células linfoides monótonas, hipercrómicas, con escaso citoplasma, similares a las observadas en Bazo y Médula ósea"> fiogf49gjkf0dInfiltración de sinusoides y espacios porta por células linfoides monótonas, hipercrómicas, con escaso citoplasma, similares a las observadas en Bazo y Médula ósea">
Fig.11: Infiltración hepática. H-E - fiogf49gjkf0d Infiltración de sinusoides y espacios porta por células linfoides monótonas, hipercrómicas, con escaso citoplasma, similares a las observadas en Bazo y Médula ósea
|
|
|
Discusión
fiogf49gjkf0d Se realizó primeramente en el año 2001, una biopsia de médula ósea con infiltración difusa (focal) por celularidad linfomatosa, informada como infiltración de médula ósea por linfoma de estirpe a determinar. El paciente no presentaba adenopatías, ni otras alteraciones. No se realiza inmunohistoquímica al no disponer en ese momento.
El paciente recibió tratamiento quimioterápico con Ciclofosfamida, Doxorubicina, Vincristina y Deltisona, sin respuesta. En el año 2003, se realiza esplenectomía, observándose infiltración sinusoidal por células monomórfas de diámetro mediano, con escaso citoplasma, con ausencia de mitosis.
El estudio inmunohistoquímico realizado sospechando un linfoma de estirpe celular B, mostró CD20-, CD79a-, cadenas livinas de inmunoglobulinas Kappa y Lambda negativas y CD3+. Se realizaron estudios adicionales que mostraron: CD45RO+, CD43+, CD8+, CD56-, p53-, S-100-, TIA-1+, Granzime B-, Perforina-, Ki-67- Informandose como linfoma T hepato-esplenico. Se solicita biopsia hepática que muestra infiltración sinusoidal y portal por celulas monomorfas con similares caracteres citológicos a los evaluados en bazo.
Se realiza una segunda línea de terapia con MINE (Mitoxantrona, Iofosfamida, Mesna y Etopoxico).
Este caso presenta caracteres clínicos patológicos de un linfoma que Hepatoesplénico, entidad primeramente descrita como linfoma γ/δ Hepatoesplénico de cuál se ha descripto una variedad llamada linfoma α/β Hepatoesplénico.
El estudio de TCR para α/β o γ/δ sólo es posible de realizar sobre materiales en fresco, no pudiendo realizarse este estudio, ya que se recibió fijado el bazo. Se diagnosticó como linfoma T Hepatoesplénico. Es el único caso de este tipo que registramos, entre 528 casos de linfomas de nuestro archivo y entre 242 casos de linfomas extraganglionares.
Sin embargo presenta algunas particularidades. La biopsia medular no presenta el característico patrón sinusoidal descrípto en este tipo de linfomas. Por el contrario la infiltración medular fue masiva ocupando todo el espacio medular entre algunas trabéculas óseas. La biopsia hepática muestra además del patrón sinusoidal, infiltración portal moderada. Por último la evolución sin respuesta a terapia, realizandose en 2005 una nueva biopsia medular, que muestra persistencia de la infiltración medular. El paciente se halla vivo a 5 años de la biopsia inicial.
Si bien en la primera biopsia medular no se observa el cuadro sinusoidal descrípto, no se realizó estudio de inmunohistoquímica, pudiendo este patrón estar oculto en la médula ósea hipercelular.
El caso se recibió sin datos clínicos y ante el sorpresivo resultado de CD3+, se obtuvieron los datos pertinentes de hematología referentes a la presencia de anemia, trombocitopenia y mialgias. Esto revaloriza lo vital de disponer de adecuados datos clínicos en los estudios de patología hemo-linfo-poyética, que lamentablemente en nuestro medio son dificultosos de conseguir.
|
|
|
Conclusiones
fiogf49gjkf0d Se presenta un caso de linfoma T hepatoesplenico, en paciente de sexo masculino de 35 años de edad, con fiebre, hepatoesplenomegalia, anemia moderada, neutropenia, trombocitopenia y mialgias. El bazo masivamente agrandado con 3,5 kg de peso y presencia de células linfomatosas en médula ósea, bazo e hígado. Caracteres todos ellos vinculables a un linfoma T hepatoesplenico.
Sin embargo a nivel medular, no presenta el característico patrón sinusoidal descrípto en la literatura, pero referido en casos tardíos. Este podría ser la explicación para este característica morfológica. Se menciona en la literatura que la infiltración medular es tan característica que es suficiente para establecer un diagnóstico de esta naturaleza. Pero en nuestro caso el patrón medular no permitía la sospecha de un linfoma T, evaluandose como un linfoma B, con resultados negativos en la evaluación inmunohistoquímica. Sin embargo la evolución tampoco fué la esperada en un caso tardío, ya que el paciente permanece vivo, con infiltración medular linfomatosa a 5 años del diagnóstico original. Por lo tanto se trata de un caso de linfoma T hepatoesplenico con característico cuadro clínico, con variantes morfológicas y evolución atípica para esta afección.
|
|
|
Bibliografía
1) Jaffe ES, Syein H, Harrys NL, Vardinam J. Tumours of Haematopoietic and Lymphoid Tissues. Pathology and Genetic. IARC Press. Blue Books, World Health Organization. 2001.
2) Farcet JP, Gaulard P, Marolleau y col. Hepatosplenic T-cell Lymphoma: Sinusal/Sinusoidal
localization of malignant cells expressing the T-cell receptor delta/gamma.
Blood 1990;75:2213-2219.
3) Cooke CB, Krenakcs L, Stetler-Stevenson M, y col. Hepatosplenic T-cell Lymphoma: A distinct clinicopathologic entity
of cytotoxic delta/gamma T-cell origin.
4) Oshima K, Haraoka S, Harada N y col.
Hepatosplenic T-cell lymphoma: relation to Epstein-Barr virus and activated cytotoxic molecules.
Histopathology 2000;36: 127-135
5) Belhaj K, Reyes F, Farcet JP y col.
Hepatosplenic T-cell Lymphoma is a rare clinicopathologic entity with poor outcome: report on a series of 21 patients.
Blood 2003;102:4261-4269
6) Hanson C, Bockenstedt P, Schnitzer B y col.
S-100-positive, T-cell Chronic Lymphproliferative Disease: An agressive disease of an uncommon T-cell subset.
Blood 1991; 78:1803-1813.
7) Gaulard P, Belhadj K, Reyes F.
Delta/gamma T-cell Lymphomas.
Seminars in Hematology. 2003;40:233-234.
|
|
|
Comentarios
- Agustín Acevedo Barberá (25/10/2005 16:53:00)
Me parece un extraño caso y no sabría muy bien, a la vista de la historia y de la iconografía presentada, como clasificarlo. No todos los linfomas deben encuadrarse obligatoriamente en una de las entidades propuestas por la OMS. Respecto a lo que afirma en el texto acerca de la distinción entre linfocitos alfa/beta y gamma/delta existe un anticuerpo monoclonal (beta-F1) de la casa Endogen que reconoce la configuración alfa/beta del TcR en tejidos fijados en formol e incluidos en parafina. En este y en otros casos de linfomas T como los que presenta en otras comunicaciones podría aportar datos de interés.
|
|
|
|
|

 Comunciación libre
Comunciación libre